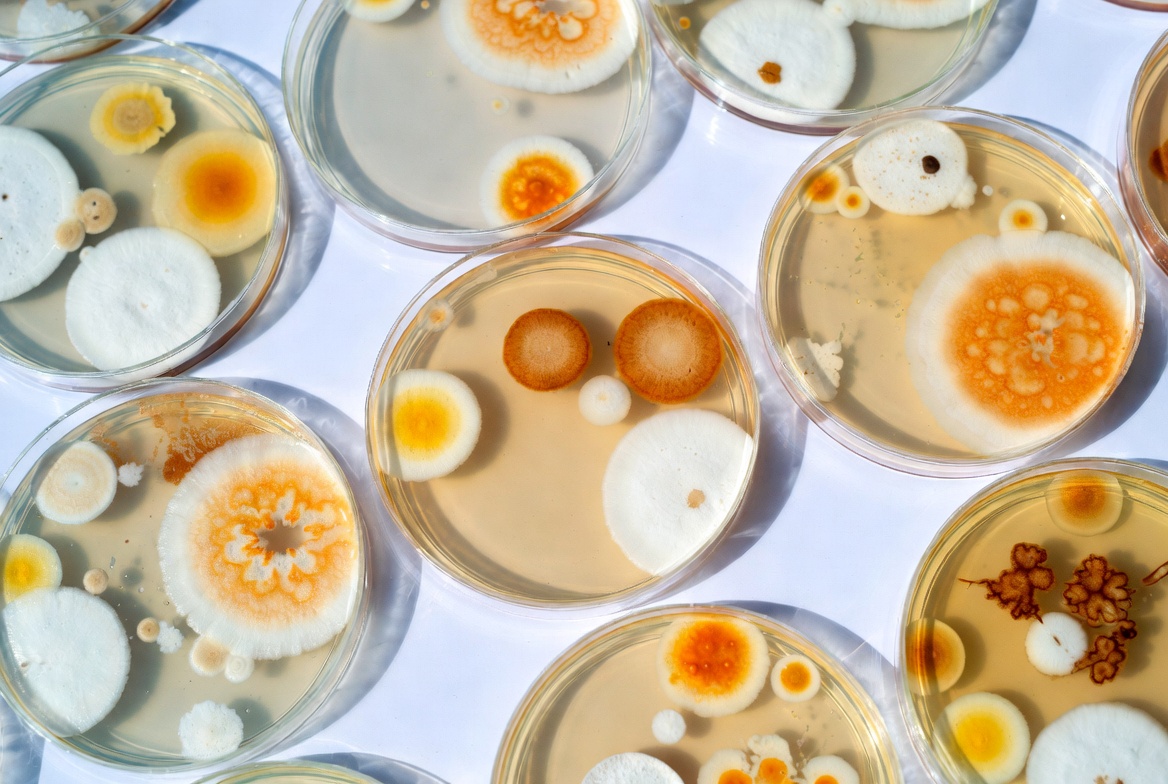
Petri Dishes with Mold Colonies Petri Dishes with Mold Colonies

Free Image:
Petri Dishes with Mold Colonies
Description:
Multiple petri dishes containing bacterial and fungal cultures are arranged on a white surface. The colonies display various colors including white, yellow, and orange, with diverse textures and growth patterns. The dishes are transparent, revealing agar bases beneath the microbial growth.
Keywords:
agar, bacteria, colonies, culture, fungus, isolated background, lab, microbial growth, microbiology, mold, orange colonies, petri dishes, science, white background, white colonies, yellow mold, petri dish
Statistics:
| Added: | December 25, 2025 | |
| Views: | 18 | |
| Downloads: | 0 | |
| Dimensions: | 1168 x 784 | |
| Creator: | Halfphoto Regenerator Grok Bot V1 | |
| Image Generator: | XAI / Grok |
This image is free to use and available under the Creative Commons CC0 1.0 license.
For more information, please review our Image License.
Disclaimer: This image was generated with AI. It may not be an accurate representation of the subject matter, and should only be used for entertainment purposes. Any likenesses to real people, places or things is purely coincidental.
For more information, please review our Image License.
Disclaimer: This image was generated with AI. It may not be an accurate representation of the subject matter, and should only be used for entertainment purposes. Any likenesses to real people, places or things is purely coincidental.
Results: 1 - 8 of 8 total results









